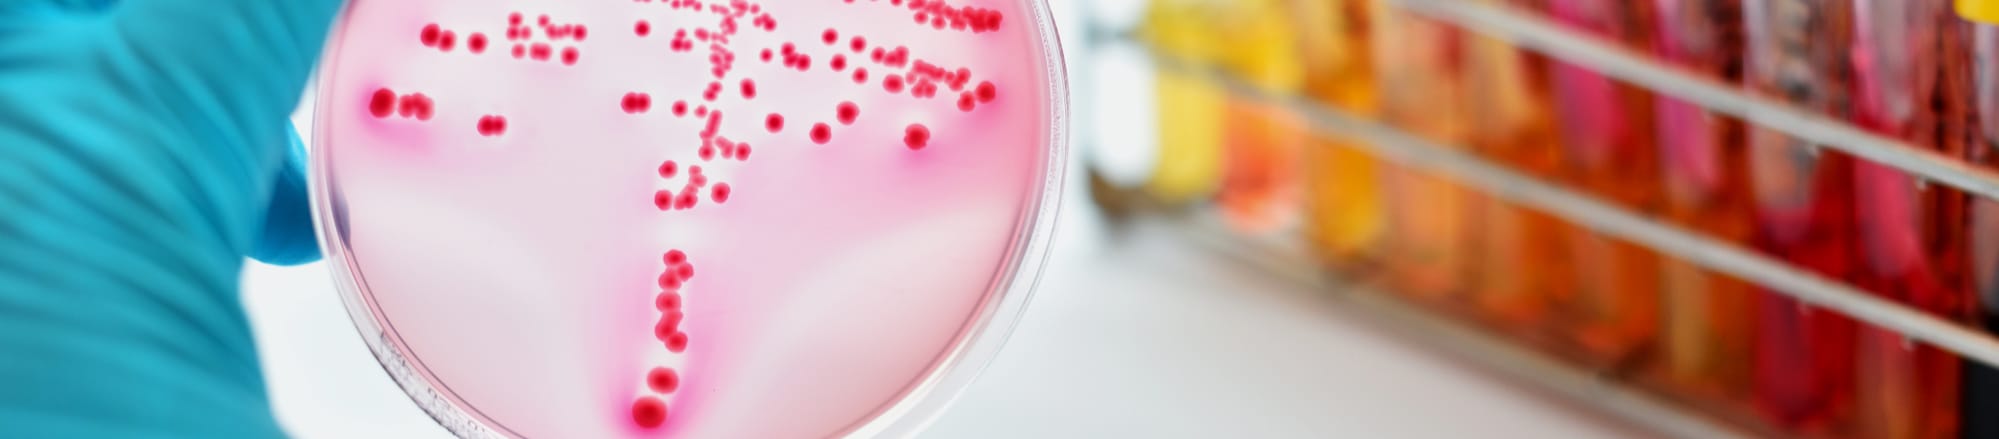

この検査で調べることのできるサルモネラ属菌や腸管出血性大腸菌などの細菌は、 自覚症状や発症していなくても腸内に保菌してしまうことがあります。
保菌した方が食品の取り扱いや介護などに従事した場合、食品を汚染させてしまったり、他人へ感染させてしまう恐れがあります。 食品衛生法では定期的に検便検査を行うことが義務づけられていますので、 食品を取り扱う前には、検便検査を行うことをお勧めいたします。
この検査で調べることのできるサルモネラ属菌や腸管出血性大腸菌などの細菌は、 自覚症状や発症していなくても腸内に保菌してしまうことがあります。
保菌した方が食品の取り扱いや介護などに従事した場合、食品を汚染させてしまったり、他人へ感染させてしまう恐れがあります。 食品衛生法では定期的に検便検査を行うことが義務づけられていますので、 食品を取り扱う前には、検便検査を行うことをお勧めいたします。